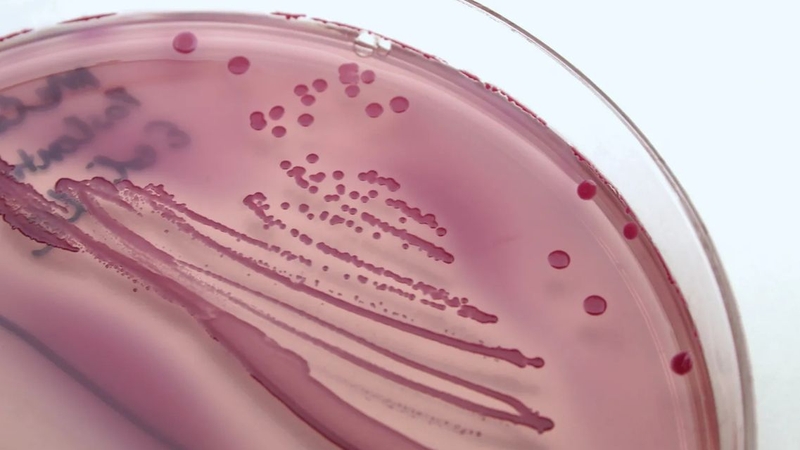
Cấy dịch niệu đạo giúp xác định tác nhân gây viêm nhiễm đường sinh dục - tiết niệu

Tốt nghiệp Đại học Y Dược TP. Hồ Chí Minh. Có nhiều năm trong lĩnh vực dược phẩm. Hiện đang là giảng viên cho Dược sĩ tại Nhà thuốc Long Châu.
Thanh Hương
27/01/2026
Mặc định
Lớn hơn
Cấy dịch niệu đạo là một xét nghiệm quan trọng giúp xác định chính xác tác nhân gây viêm nhiễm đường sinh dục. Trong bài viết này, chúng ta sẽ cùng tìm hiểu rõ cấy dịch niệu đạo là gì và khi nào cần thực hiện.
Cấy dịch niệu đạo là một trong những xét nghiệm quan trọng giúp phát hiện chính xác tác nhân gây viêm nhiễm đường sinh dục - tiết niệu. Thực hiện cấy dịch niệu đạo không chỉ giúp chẩn đoán đúng nguyên nhân bệnh mà còn góp phần điều trị kịp thời, bảo vệ sức khỏe sinh sản.
Cấy dịch niệu đạo là một xét nghiệm vi sinh được thực hiện bằng cách lấy mẫu dịch tiết từ niệu đạo và nuôi cấy trong môi trường chuyên biệt nhằm phát hiện một số vi khuẩn, nấm hoặc các tác nhân gây nhiễm trùng. Xét nghiệm này giúp xác định một số tác nhân gây viêm niệu đạo hoặc viêm đường tiết niệu có khả năng nuôi cấy được. Đối với các bệnh lây truyền qua đường tình dục do tác nhân không nuôi cấy thường quy, cần thực hiện các xét nghiệm sinh học phân tử để chẩn đoán chính xác
Thông qua kết quả cấy dịch niệu đạo, bác sĩ có thể đánh giá mức độ nhiễm trùng và lựa chọn kháng sinh phù hợp, hạn chế tình trạng điều trị sai thuốc hoặc kháng thuốc. Đây là xét nghiệm quan trọng trong chẩn đoán và theo dõi điều trị các bệnh viêm niệu đạo, đặc biệt ở nam giới.
Cấy dịch niệu đạo thường được bác sĩ chỉ định trong một số trường hợp sau:
Cấy dịch niệu đạo được chỉ định khi người bệnh có các triệu chứng như tiểu buốt, tiểu rát, chảy dịch niệu đạo, ngứa hoặc đau dọc niệu đạo kéo dài. Xét nghiệm giúp xác định chính xác tác nhân gây viêm để điều trị dứt điểm, tránh tái phát nhiều lần.
Trong trường hợp có quan hệ tình dục không an toàn hoặc tiếp xúc với người nghi mắc bệnh, cấy dịch niệu đạo có thể được chỉ định để phát hiện một số tác nhân có khả năng nuôi cấy được, đặc biệt là Neisseria gonorrhoeae (lậu cầu) và một số vi khuẩn hiếu khí khác.
Đối với các tác nhân gây bệnh lây truyền qua đường tình dục không nuôi cấy thường quy như Chlamydia trachomatis hoặc Mycoplasma genitalium, cần thực hiện xét nghiệm sinh học phân tử (NAAT/PCR) để chẩn đoán chính xác.
Nếu các triệu chứng viêm niệu đạo không cải thiện hoặc tái phát sau khi dùng thuốc, cấy dịch niệu đạo giúp xác định tình trạng kháng kháng sinh, từ đó bác sĩ điều chỉnh phác đồ điều trị phù hợp và hiệu quả hơn.
Trong nhiều trường hợp, bác sĩ chỉ định cấy dịch niệu đạo ngay từ đầu nhằm xác định chính xác vi khuẩn hoặc nấm gây bệnh, giúp lựa chọn thuốc đặc hiệu và giảm nguy cơ biến chứng.
Cấy dịch niệu đạo có thể được thực hiện sau điều trị để kiểm tra tình trạng nhiễm trùng đã được kiểm soát hoàn toàn hay chưa, đặc biệt ở những trường hợp viêm nặng hoặc có nguy cơ tái nhiễm cao.

Việc lấy mẫu cấy dịch niệu đạo cần được thực hiện đúng kỹ thuật và đúng thời điểm để đảm bảo kết quả xét nghiệm chính xác.
Mẫu dịch được lấy trực tiếp tại lỗ niệu đạo, bằng tăm bông vô trùng chuyên dụng. Nhân viên y tế sẽ đưa nhẹ đầu tăm bông vào trong niệu đạo một đoạn ngắn để thấm dịch tiết, sau đó bảo quản và chuyển mẫu đến phòng xét nghiệm. Quy trình này diễn ra nhanh, hạn chế xâm lấn và đảm bảo an toàn cho người bệnh.
Thời điểm lấy mẫu cấy dịch niệu đạo lý tưởng là trước khi sử dụng kháng sinh hoặc ít nhất sau khi ngưng thuốc theo hướng dẫn của bác sĩ, nhằm tránh làm sai lệch kết quả. Ngoài ra, người bệnh thường được khuyến cáo không đi tiểu trong 2 - 4 giờ trước khi lấy mẫu để đảm bảo lượng vi sinh vật trong dịch niệu đạo đủ cho việc nuôi cấy và phát hiện chính xác.
Quy trình thực hiện cấy dịch niệu đạo được tiến hành theo các bước chuẩn y khoa nhằm đảm bảo lấy mẫu đúng kỹ thuật và cho kết quả chính xác.

Chi phí cấy dịch niệu đạo có thể khác nhau tùy vào cơ sở y tế, loại xét nghiệm (chỉ nuôi cấy hoặc kèm thử nghiệm kháng sinh) và các dịch vụ bổ sung khác.
Chi phí cấy dịch niệu đạo không cố định, phụ thuộc vào cơ sở y tế, loại vi sinh vật cần nuôi cấy và việc có thực hiện kháng sinh đồ hay không. Người bệnh nên tham khảo bảng giá niêm yết chính thức tại cơ sở y tế công lập để biết chi phí cụ thể. Theo thực tế triển khai tại các cơ sở y tế, chi phí cấy dịch niệu đạo thường dao động trong khoảng 150.000 - 500.000 VNĐ, tùy loại xét nghiệm và quy định của từng cơ sở.
Để biết chi phí chính xác, người bệnh nên liên hệ trực tiếp với cơ sở y tế hoặc phòng khám nơi dự định làm xét nghiệm.
Trước khi cấy dịch niệu đạo, người bệnh nên ngưng sử dụng kháng sinh theo hướng dẫn của bác sĩ trước khi lấy mẫu, vì thuốc có thể làm giảm số lượng vi khuẩn và gây sai lệch kết quả. Trước khi xét nghiệm, cần không đi tiểu trong khoảng 2 - 4 giờ, tránh thụt rửa niệu đạo hoặc sử dụng dung dịch sát khuẩn vùng sinh dục để đảm bảo mẫu dịch đạt chất lượng tốt nhất.

Sau khi lấy mẫu, người bệnh có thể cảm thấy khó chịu nhẹ hoặc rát thoáng qua tại niệu đạo, đây là hiện tượng bình thường và sẽ tự hết. Người bệnh nên tuân thủ hướng dẫn chăm sóc và điều trị của bác sĩ, tránh quan hệ tình dục cho đến khi có kết quả và hoàn tất điều trị nếu được chỉ định, nhằm hạn chế lây nhiễm và bảo vệ sức khỏe sinh dục.
Cấy dịch niệu đạo không chỉ giúp chẩn đoán chính xác các bệnh viêm nhiễm đường sinh dục mà còn góp phần phòng ngừa biến chứng và lây nhiễm. Khi xuất hiện dấu hiệu bất thường hoặc thuộc nhóm nguy cơ, người bệnh nên chủ động đi khám và thực hiện xét nghiệm theo chỉ định của bác sĩ để bảo vệ sức khỏe.
Dược sĩ Đại họcNguyễn Vũ Kiều Ngân
Tốt nghiệp Đại học Y Dược TP. Hồ Chí Minh. Có nhiều năm trong lĩnh vực dược phẩm. Hiện đang là giảng viên cho Dược sĩ tại Nhà thuốc Long Châu.